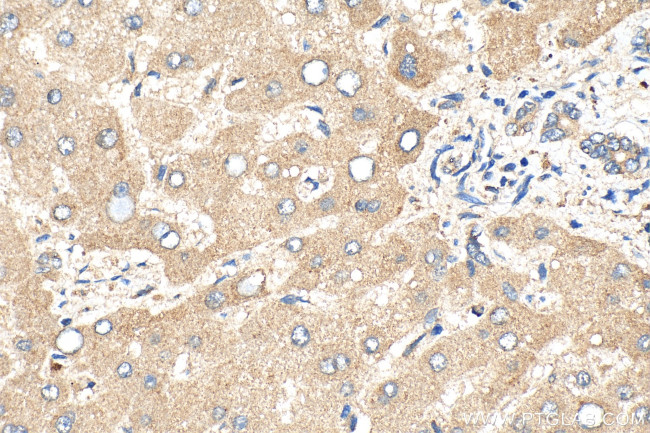
CYP4F2 Antibody in Immunohistochemistry (Paraffin) (IHC (P))

Search
Proteintech
CYP4F2 Polyclonal Antibody
{{$productOrderCtrl.translations['antibody.pdp.commerceCard.promotion.promotions']}}
{{$productOrderCtrl.translations['antibody.pdp.commerceCard.promotion.viewpromo']}}
{{$productOrderCtrl.translations['antibody.pdp.commerceCard.promotion.promocode']}}: {{promo.promoCode}} {{promo.promoTitle}} {{promo.promoDescription}}. {{$productOrderCtrl.translations['antibody.pdp.commerceCard.promotion.learnmore']}}
产品信息
20010-1-AP
种属反应
宿主/亚型
分类
类型
抗原
偶联物
形式
浓度
规格
纯化类型
保存液
内含物
保存条件
运输条件
靶标信息
CYP4F isoforms are involved in the oxidation of important cellular mediators, such as leukotriene B4 (LTB4) and prostaglandins. CYP4F2 catalyzes omega-hydroxylation of LTB4 to a less potent proinflammatory eicosanoid, 20-OH-LTB4 as well as arachidonic acid. CYP4F2 is expressed in liver and kidney. Its expression is repressed by peroxisomal proliferators and induced by retinoic acid. X-linked adrenoleukodystrophy (X-ALD) is a severe neurodegenerative disorder biochemically characterized by elevated levels of very long-chain fatty acids (VLCFA). CYP4F2 participates in the omega-hydroxylation of VLCFAs, which may provide an alternative mode of treatment for X-ALD patients.
仅用于科研。不用于诊断过程。未经明确授权不得转售。
篇参考文献 (0)
生物信息学
蛋白别名: 20-HETE synthase; 20-hydroxyeicosatetraenoic acid synthase; Arachidonic acid omega-hydroxylase; CYPIVF2; Cytochrome P450 4F2; cytochrome P450, family 4, subfamily F, polypeptide 2; cytochrome P450, subfamily IVF, polypeptide 2; Cytochrome P450-LTB-omega; Docosahexaenoic acid omega-hydroxylase; Leukotriene-B(4) 20-monooxygenase 1; Leukotriene-B(4) omega-hydroxylase 1; Phylloquinone omega-hydroxylase CYP4F2; unnamed protein product
基因别名: CPF2; CYP4F2
UniProt ID: (Human) P78329
Entrez Gene ID: (Human) 8529